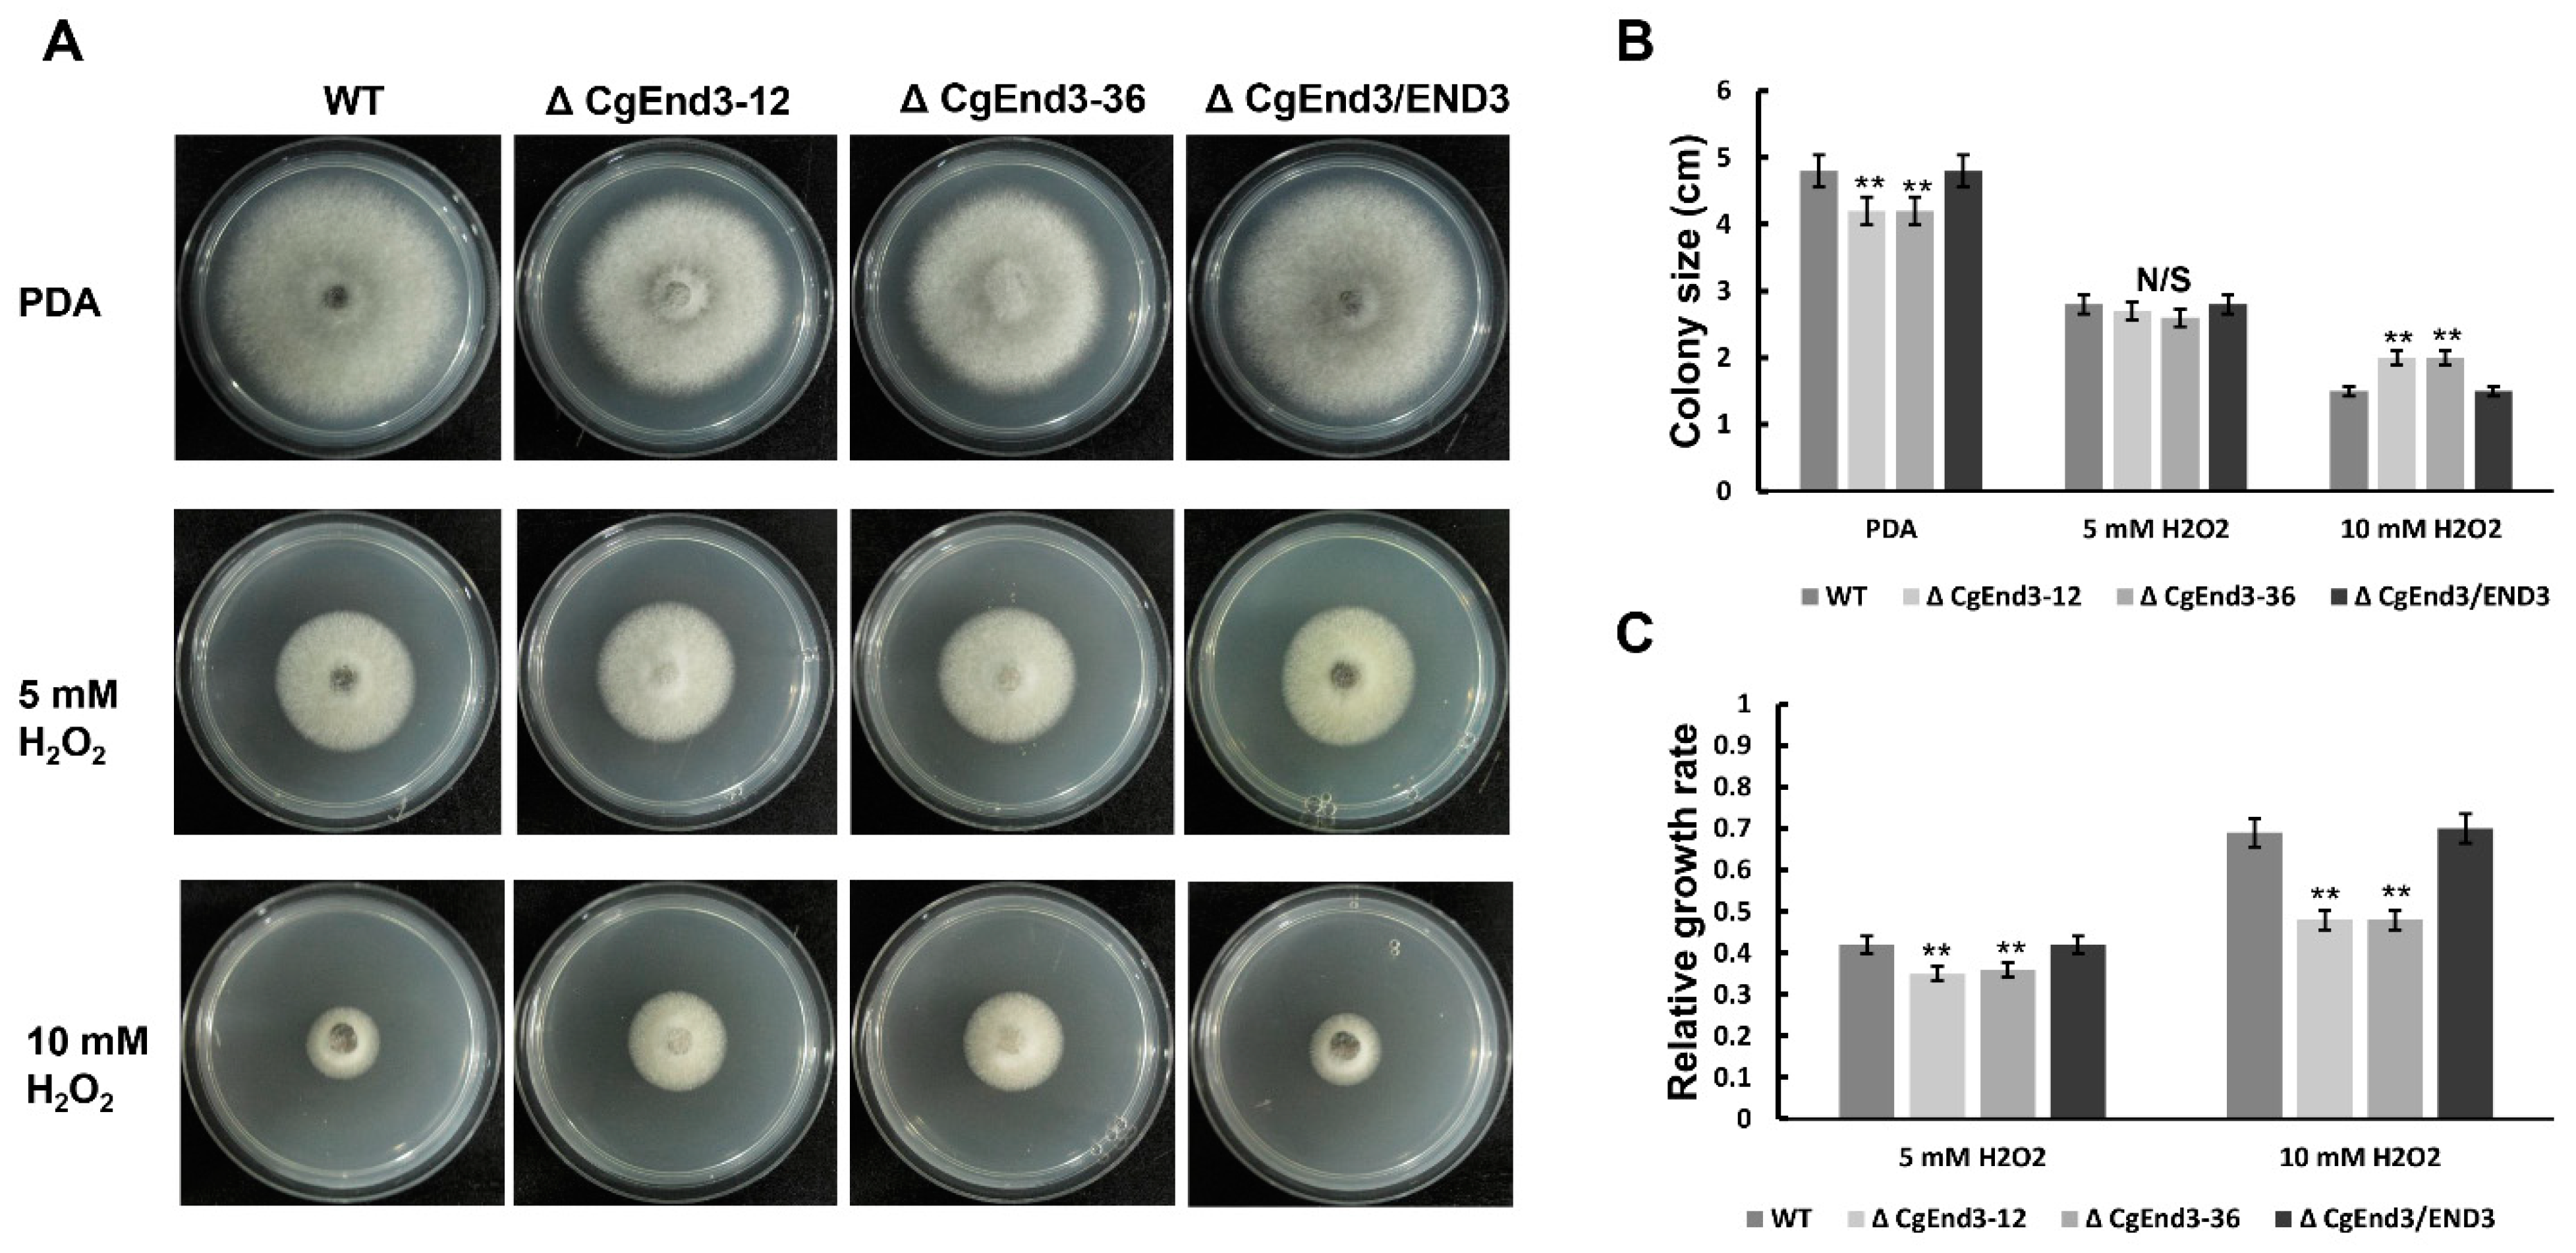
Ijms 22 04029 g004

CgEnd3 Regulates Endocytosis, Appressorium Formation, and Virulence in the Poplar Anthracnose Fungus Colletotrichum gloeosporioides
Abstract
1. Introduction
2. Results
2.1. CgEnd3 Is Required for Endocytosis
2.2. Deletion of CgEnd3 Resulted in the Defect of Appressorium Formation, Melanization, Polarity, Penetration and Invasive Growth
2.3. Turgor Pressure Is Decreased in ΔCgEnd3
2.4. ΔCgEnd3 Loses the Ability of Cellophane Membrane Penetration
2.5. CgEnd3 Is Involved in Oxidant Adaptation and the Regulation of Effectors during Early Infection Stage
2.6. CgEnd3 Is Required for the Full Virulence
2.7. CgEnd3 Involved in the Calcium Signaling in C. gloeosporioides
2.8. CgEnd3 Is Required for Cell Wall Integrity
2.9. Lack of CgEnd3 Resulted in Increased Resistance to Fungicide Fludioxonil
3. Discussion
4. Materials and Methods
4.1. Cultivation of Fungi
4.2. Isolation and Phylogenetic Analysis of CgEnd3
4.3. Generation of CgEnd3 Deletion Mutants
4.4. Gene Expression Analysis
4.5. Fungicide Response Assay
4.6. Cellophane Membrane Penetration Assays
4.7. Pathogenicity Assay
4.8. DAB and FM4-64 Staining
Supplementary Materials
Author Contributions
Funding
Institutional Review Board Statement
Informed Consent Statement
Data Availability Statement
Acknowledgments
Conflicts of Interest
References
- Kim, J.W.; Shim, S.H. The fungus Colletotrichum as a source for bioactive secondary metabolites. Arch. Pharmacal Res. 2019, 42, 735–753. [Google Scholar] [CrossRef]
- Li, Z.; Liang, Y.-M.; Tian, C. Characterization of the causal agent of poplar anthracnose occurring in the Beijing region. Mycotaxon 2012, 120, 277–286. [Google Scholar] [CrossRef]
- Xu, X.; Wang, Y.; Tian, C.; Liang, Y. The Colletotrichum gloeosporioides RhoB regulates cAMP and stress response pathways and is required for pathogenesis. Fungal Genet. Biol. B 2016, 96, 12–24. [Google Scholar] [CrossRef]
- Sun, Y.; Wang, Y.; Tian, C. bZIP transcription factor CgAP1 is essential for oxidative stress tolerance and full virulence of the poplar anthracnose fungus Colletotrichum gloeosporioides. Fungal Genet. Biol. B 2016, 95, 58–66. [Google Scholar] [CrossRef]
- Talbot, N. Appressoria. Curr. Biol. 2019, 29, R144–R146. [Google Scholar] [CrossRef]
- Zhang, X.; Zhang, J.; He-Pu, H.; Wang, X.; Tian, C. Histopathology study of poplar leaves infected by Colletotrichum gloeosporioides. Beijing Linye Daxue Xuebao/J. Beijing For. Univ. 2018, 40, 101–109. [Google Scholar] [CrossRef]
- Kumamoto, C.A. Molecular mechanisms of mechanosensing and their roles in fungal contact sensing. Nat. Rev. Microbiol. 2008, 6, 667–673. [Google Scholar] [CrossRef] [PubMed]
- DeZwaan, T.M.; Carroll, A.M.; Valent, B.; Sweigard, J.A. Magnaporthe grisea pth11p is a novel plasma membrane protein that mediates appressorium differentiation in response to inductive substrate cues. Plant Cell 1999, 11, 2013–2030. [Google Scholar] [CrossRef] [PubMed]
- Kou, Y.; Tan, Y.H.; Ramanujam, R.; Naqvi, N.I. Structure-function analyses of the Pth11 receptor reveal an important role for CFEM motif and redox regulation in rice blast. New Phytol. 2017, 214, 330–342. [Google Scholar] [CrossRef]
- Lanver, D.; Mendoza-Mendoza, A.; Brachmann, A.; Kahmann, R. Sho1 and Msb2-related proteins regulate appressorium development in the smut fungus Ustilago maydis. Plant Cell 2010, 22, 2085–2101. [Google Scholar] [CrossRef]
- Liu, W.; Zhou, X.; Li, G.; Li, L.; Kong, L.; Wang, C.; Zhang, H.; Xu, J.R. Multiple plant surface signals are sensed by different mechanisms in the rice blast fungus for appressorium formation. PLoS Pathog. 2011, 7, e1001261. [Google Scholar] [CrossRef]
- Saunders, D.G.; Aves, S.J.; Talbot, N.J. Cell cycle-mediated regulation of plant infection by the rice blast fungus. Plant Cell 2010, 22, 497–507. [Google Scholar] [CrossRef] [PubMed]
- Castanheira, S.; Mielnichuk, N.; Pérez-Martín, J. Programmed cell cycle arrest is required for infection of corn plants by the fungus Ustilago maydis. Development 2014, 141, 4817–4826. [Google Scholar] [CrossRef] [PubMed]
- Veneault-Fourrey, C.; Barooah, M.; Egan, M.; Wakley, G.; Talbot, N.J. Autophagic fungal cell death is necessary for infection by the rice blast fungus. Science 2006, 312, 580–583. [Google Scholar] [CrossRef]
- Wang, Z.Y.; Jenkinson, J.M.; Holcombe, L.J.; Soanes, D.M.; Veneault-Fourrey, C.; Bhambra, G.K.; Talbot, N.J. The molecular biology of appressorium turgor generation by the rice blast fungus Magnaporthe grisea. Biochem. Soc. Trans. 2005, 33, 384–388. [Google Scholar] [CrossRef]
- Money, N.; Howard, R. Confirmation of a Link between Fungal Pigmentation, Turgor Pressure, and Pathogenicity Using a New Method of Turgor Measurement. Fungal Genet. Biol. 1996, 20, 217–227. [Google Scholar] [CrossRef]
- Chumley, F.; Valent, B. Genetic analysis of melanin-deficient, nonpathogenic mutants of Magnaporthe grisea. Mol. Plant-Microbe Interact. 1990, 3, 135–143. [Google Scholar] [CrossRef]
- Ryder, L.; Dagdas, Y.; Kershaw, M.; Venkataraman, C.; Madzvamuse, A.; Yan, X.; Cruz-Mireles, N.; Soanes, D.; Oses-Ruiz, M.; Styles, V.; et al. A sensor kinase controls turgor-driven plant infection by the rice blast fungus. Nature 2019, 574, 1–5. [Google Scholar] [CrossRef]
- Huser, A.; Takahara, H.; Schmalenbach, W.; O’Connell, R. Discovery of pathogenicity genes in the crucifer anthracnose fungus Colletotrichum higginsianum, using random insertional mutagenesis. Mol. Plant Microbe Interact. 2009, 22, 143–156. [Google Scholar] [CrossRef]
- Takano, Y.; Kubo, Y.; Kuroda, I.; Furusawa, I. Temporal Transcriptional Pattern of Three Melanin Biosynthesis Genes, PKS1, SCD1, and THR1, in Appressorium-Differentiating and Nondifferentiating Conidia of Colletotrichum lagenarium. Appl. Environ. Microbiol. 1997, 63, 351–354. [Google Scholar] [CrossRef]
- Perpetua, N.S.; Kubo, Y.; Yasuda, N.; Takano, Y.; Furusawa, I. Cloning and characterization of a melanin biosynthetic THR1 reductase gene essential for appressorial penetration of Colletotrichum lagenarium. Mol. Plant Microbe Interact. 1996, 9, 323–329. [Google Scholar] [CrossRef]
- Kubo, Y. Cloning of a Melanin Biosynthetic Gene Essential for Appressorial Penetration of Colletotrichum lagenarium. Mol. Plant-Microbe Interact. 1991, 4, 440. [Google Scholar] [CrossRef]
- Kubo, Y.; Takano, Y.; Endo, N.; Yasuda, N.; Tajima, S.; Furusawa, I. Cloning and structural analysis of the melanin biosynthesis gene SCD1 encoding scytalone dehydratase in Colletotrichum lagenarium. Appl. Environ. Microbiol. 1997, 62, 4340–4344. [Google Scholar] [CrossRef]
- Wang, T.; Ren, D.; Guo, H.; Chen, X.; Zhu, P.; Nie, H.; Xu, L. CgSCD1 Is Essential for Melanin Biosynthesis and Pathogenicity of Colletotrichum gloeosporioides. Pathogens 2020, 9, 141. [Google Scholar] [CrossRef]
- Kleemann, J.; Rincon-Rivera, L.J.; Takahara, H.; Neumann, U.; Ver Loren van Themaat, E.; van der Does, H.C.; Hacquard, S.; Stüber, K.; Will, I.; Schmalenbach, W.; et al. Sequential delivery of host-induced virulence effectors by appressoria and intracellular hyphae of the phytopathogen Colletotrichum higginsianum. PLoS Pathog. 2012, 8, e1002643. [Google Scholar] [CrossRef]
- Irieda, H.; Maeda, H.; Akiyama, K.; Hagiwara, A.; Saitoh, H.; Uemura, A.; Terauchi, R.; Takano, Y. Colletotrichum orbiculare Secretes Virulence Effectors to a Biotrophic Interface at the Primary Hyphal Neck via Exocytosis Coupled with SEC22-Mediated Traffic. Plant Cell 2014, 26, 2265–2281. [Google Scholar] [CrossRef] [PubMed]
- Giraldo, M.C.; Dagdas, Y.F.; Gupta, Y.K.; Mentlak, T.A.; Yi, M.; Martinez-Rocha, A.L.; Saitoh, H.; Terauchi, R.; Talbot, N.J.; Valent, B. Two distinct secretion systems facilitate tissue invasion by the rice blast fungus Magnaporthe oryzae. Nat. Commun. 2013, 4, 1996. [Google Scholar] [CrossRef] [PubMed]
- Wilson, R.A.; Talbot, N.J. Under pressure: Investigating the biology of plant infection by Magnaporthe oryzae. Nat. Rev. Microbiol. 2009, 7, 185–195. [Google Scholar] [CrossRef]
- Carafoli, E. Calcium signaling: A tale for all seasons. Proc. Natl. Acad. Sci. USA 2002, 99, 1115–1122. [Google Scholar] [CrossRef]
- Wachten, D.; Roderick, H.; Bootman, M. Intracellular Calcium Signaling. Handb. Cell Signal. 2010, 2, 937–942. [Google Scholar] [CrossRef]
- Chin, D.; Means, A. Calmodulin: A prototypical calcium sensor. Trends Cell Biol. 2000, 10, 322–328. [Google Scholar] [CrossRef]
- Harel, A.; Bercovich, S.; Yarden, O. Calcineurin is required for sclerotial development and pathogenicity of Sclerotinia sclerotiorum in an oxalic acid-independent manner. Mol. Plant Microbe Interact. 2006, 19, 682–693. [Google Scholar] [CrossRef] [PubMed]
- Hernández-Ortiz, P.; Espeso, E.A. Phospho-regulation and nucleocytoplasmic trafficking of CrzA in response to calcium and alkaline-pH stress in Aspergillus nidulans. Mol. Microbiol. 2013, 89, 532–551. [Google Scholar] [CrossRef]
- Park, H.S.; Lee, S.C.; Cardenas, M.E.; Heitman, J. Calcium-Calmodulin-Calcineurin Signaling: A Globally Conserved Virulence Cascade in Eukaryotic Microbial Pathogens. Cell Host Microbe 2019, 26, 453–462. [Google Scholar] [CrossRef] [PubMed]
- Choi, J.; Kim, Y.; Kim, S.; Park, J.; Lee, Y.H. MoCRZ1, a gene encoding a calcineurin-responsive transcription factor, regulates fungal growth and pathogenicity of Magnaporthe oryzae. Fungal Genet. Biol. B 2009, 46, 243–254. [Google Scholar] [CrossRef] [PubMed]
- Xiong, D.; Wang, Y.; Tang, C.; Fang, Y.; Zou, J.; Tian, C. VdCrz1 is involved in microsclerotia formation and required for full virulence in Verticillium dahliae. Fungal Genet. Biol. B 2015, 82, 201–212. [Google Scholar] [CrossRef]
- Schumacher, J.; de Larrinoa, I.F.; Tudzynski, B. Calcineurin-responsive zinc finger transcription factor CRZ1 of Botrytis cinerea is required for growth, development, and full virulence on bean plants. Eukaryot. Cell 2008, 7, 584–601. [Google Scholar] [CrossRef]
- Adamíková, L.; Straube, A.; Schulz, I.; Steinberg, G. Calcium signaling is involved in dynein-dependent microtubule organization. Mol. Biol. Cell 2004, 15, 1969–1980. [Google Scholar] [CrossRef]
- Nguyen, Q.B.; Kadotani, N.; Kasahara, S.; Tosa, Y.; Mayama, S.; Nakayashiki, H. Systematic functional analysis of calcium-signalling proteins in the genome of the rice-blast fungus, Magnaporthe oryzae, using a high-throughput RNA-silencing system. Mol. Microbiol. 2008, 68, 1348–1365. [Google Scholar] [CrossRef]
- Peñalva, M. Endocytosis in filamentous fungi: Cinderella gets her reward. Curr. Opin. Microbiol. 2010, 13, 684–692. [Google Scholar] [CrossRef]
- Fischer-Parton, S.; Parton, R.M.; Hickey, P.C.; Dijksterhuis, J.; Atkinson, H.A.; Read, N.D. Confocal microscopy of FM4-64 as a tool for analysing endocytosis and vesicle trafficking in living fungal hyphae. J. Microsc. 2000, 198, 246–259. [Google Scholar] [CrossRef] [PubMed]
- Wesp, A.; Hicke, L.; Palecek, J.; Lombardi, R.; Aust, T.; Munn, A.L.; Riezman, H. End4p/Sla2p interacts with actin-associated proteins for endocytosis in Saccharomyces cerevisiae. Mol. Biol. Cell 1997, 8, 2291–2306. [Google Scholar] [CrossRef] [PubMed]
- Yang, S.; Cope, M.J.; Drubin, D.G. Sla2p is associated with the yeast cortical actin cytoskeleton via redundant localization signals. Mol. Biol. Cell 1999, 10, 2265–2283. [Google Scholar] [CrossRef] [PubMed]
- Coccetti, P.; Nicastro, R.; Tripodi, F. Conventional and emerging roles of the energy sensor Snf1/AMPK in Saccharomyces cerevisiae. Microb. Cell 2018, 5, 482–494. [Google Scholar] [CrossRef] [PubMed]
- Tang, H.Y.; Munn, A.; Cai, M. EH domain proteins Pan1p and End3p are components of a complex that plays a dual role in organization of the cortical actin cytoskeleton and endocytosis in Saccharomyces cerevisiae. Mol. Cell. Biol. 1997, 17, 4294–4304. [Google Scholar] [CrossRef] [PubMed]
- Sun, Y.; Leong, N.; Wong, T.; Drubin, D. A Pan1/End3/Sla1 complex links Arp2/3-mediated actin assembly to sites of clathrin-mediated endocytosis. Mol. Biol. Cell 2015, 26. [Google Scholar] [CrossRef] [PubMed]
- Bénédetti, H.; Raths, S.; Crausaz, F.; Riezman, H. The END3 gene encodes a protein that is required for the internalization step of endocytosis and for actin cytoskeleton organization in yeast. Mol. Biol. Cell 1994, 5, 1023–1037. [Google Scholar] [CrossRef]
- Vanstreels, E.; Alamar, C.; Verlinden, B.; Enninghorst, A.; Loodts, J.K.A.; Tijskens, E.; Ramon, H.; Nicolaï, B. Micromechanical behaviour of onion epidermal tissue. Postharvest Biol. Technol. 2005, 37, 163–173. [Google Scholar] [CrossRef]
- Park, G.; Bruno, K.; Staiger, C.; Talbot, N.; Xu, J.-R. Independent genetic mediate turgor generation and penetration peg formation during plant infection in the rice blast fungus Magnaporthe grisea. Mol. Microbiol. 2004, 53, 1695–1707. [Google Scholar] [CrossRef]
- Gu, Q.; Chen, Y.; Liu, Y.; Zhang, C.; Ma, Z. The transmembrane protein FgSho1 regulates fungal development and pathogenicity via the MAPK module Ste50-Ste11-Ste7 in Fusarium graminearum. New Phytol. 2014, 206. [Google Scholar] [CrossRef]
- Yu, J.; Li, T.; Tian, L.; Tang, C.; Klosterman, S.; Tian, C.; Wang, Y. Two Verticillium dahliae MAPKKKs, VdSsk2 and VdSte11, Have Distinct Roles in Pathogenicity, Microsclerotial Formation, and Stress Adaptation. mSphere 2019, 4. [Google Scholar] [CrossRef]
- He, P.; Wang, Y.; Wang, X.; Zhang, X.; Tian, C. The Mitogen-Activated Protein Kinase CgMK1 Governs Appressorium Formation, Melanin Synthesis, and Plant Infection of Colletotrichum gloeosporioides. Front. Microbiol. 2017, 8, 2216. [Google Scholar] [CrossRef] [PubMed]
- Apostol, I.; Heinstein, P.F.; Low, P.S. Rapid Stimulation of an Oxidative Burst during Elicitation of Cultured Plant Cells: Role in Defense and Signal Transduction. Plant Physiol. 1989, 90, 109–116. [Google Scholar] [CrossRef] [PubMed]
- Wang, X.; Xu, X.; Liang, Y.-M.; Wang, Y.; Tian, C. A Cdc42 homolog in Colletotrichum gloeosporioides regulates morphological development and is required for ROS-mediated plant infection. Curr. Genet. 2018, 64. [Google Scholar] [CrossRef] [PubMed]
- Stephenson, S.A.; Hatfield, J.; Rusu, A.G.; Maclean, D.J.; Manners, J.M. CgDN3: An essential pathogenicity gene of colletotrichum gloeosporioides necessary to avert a hypersensitive-like response in the host Stylosanthes guianensis. Mol. Plant Microbe Interact. 2000, 13, 929–941. [Google Scholar] [CrossRef] [PubMed]
- O’Connell, R.J.; Thon, M.R.; Hacquard, S.; Amyotte, S.G.; Kleemann, J.; Torres, M.F.; Damm, U.; Buiate, E.A.; Epstein, L.; Alkan, N.; et al. Lifestyle transitions in plant pathogenic Colletotrichum fungi deciphered by genome and transcriptome analyses. Nat. Genet. 2012, 44, 1060–1065. [Google Scholar] [CrossRef] [PubMed]
- Sanz-Martín, J.M.; Pacheco-Arjona, J.R.; Bello-Rico, V.; Vargas, W.A.; Monod, M.; Díaz-Mínguez, J.M.; Thon, M.R.; Sukno, S.A. A highly conserved metalloprotease effector enhances virulence in the maize anthracnose fungus Colletotrichum graminicola. Mol. Plant Pathol. 2016, 17, 1048–1062. [Google Scholar] [CrossRef]
- Yoshino, K.; Irieda, H.; Sugimoto, F.; Yoshioka, H.; Okuno, T.; Takano, Y. Cell death of Nicotiana benthamiana is induced by secreted protein NIS1 of Colletotrichum orbiculare and is suppressed by a homologue of CgDN3. Mol. Plant Microbe Interact. 2012, 25, 625–636. [Google Scholar] [CrossRef]
- Yap, K.L.; Ames, J.B.; Swindells, M.B.; Ikura, M. Diversity of conformational states and changes within the EF-hand protein superfamily. Proteins 1999, 37, 499–507. [Google Scholar] [CrossRef]
- Weiss, J.; Burgoyne, R. EF-Hand Proteins and Calcium Sensing; Elsevier: Amsterdam, The Netherlands, 2003; Volume 2, pp. 79–82. [Google Scholar]
- Lee, S.C.; Lee, Y.H. Calcium/calmodulin-dependent signaling for appressorium formation in the plant pathogenic fungus Magnaporthe grisea. Mol. Cells 1998, 8, 698–704. [Google Scholar]
- Uhm, K.H.; Ahn, I.P.; Kim, S.; Lee, Y.H. Calcium/Calmodulin-Dependent Signaling for Prepenetration Development in Colletotrichum gloeosporioides. Phytopathology 2003, 93, 82–87. [Google Scholar] [CrossRef]
- Rogers, H.; Perkins, H.; Ward, J. Cell Walls of Filamentous Fungi; ASM Press: Washington, DC, USA, 1980; pp. 469–477. [Google Scholar]
- Yang, J.; Zhang, K.Q. Chitin Synthesis and Degradation in Fungi: Biology and Enzymes. Adv. Exp. Med. Biol. 2019, 1142, 153–167. [Google Scholar] [CrossRef] [PubMed]
- Rodríguez-Quiñones, J.F.; Rodríguez-Medina, J.R. Differential gene expression signatures for cell wall integrity found in chitin synthase II (chs2Delta) and myosin II (myo1Delta) deficient cytokinesis mutants of Saccharomyces cerevisiae. BMC Res. Notes 2009, 2, 87. [Google Scholar] [CrossRef] [PubMed]
- Zhang, J.; Jiang, H.; Du, Y.; Keyhani, N.O.; Xia, Y. Members of chitin synthase family in Metarhizium acridum differentially affect fungal growth, stress tolerances, cell wall integrity and virulence. PLoS Pathog. 2019, 15, e1007964. [Google Scholar] [CrossRef] [PubMed]
- Zhang, Y.Z.; Chen, Q.; Liu, C.H.; Liu, Y.B.; Yi, P.; Niu, K.X.; Wang, Y.Q.; Wang, A.Q.; Yu, H.Y.; Pu, Z.E.; et al. Chitin synthase gene FgCHS8 affects virulence and fungal cell wall sensitivity to environmental stress in Fusarium graminearum. Fungal Biol. 2016, 120, 764–774. [Google Scholar] [CrossRef]
- Soulié, M.C.; Piffeteau, A.; Choquer, M.; Boccara, M.; Vidal-Cros, A. Disruption of Botrytis cinerea class I chitin synthase gene Bcchs1 results in cell wall weakening and reduced virulence. Fungal Genet. Biol. B. 2003, 40, 38–46. [Google Scholar] [CrossRef]
- Juvvadi, P.; Lee, S.C.; Heitman, J.; Steinbach, W. Calcineurin in Fungal Virulence and Drug Resistance: Prospects for Harnessing Targeted Inhibition of Calcineurin for an Antifungal Therapeutic Approach. Virulence 2016, 8, 186–197. [Google Scholar] [CrossRef] [PubMed]
- Li, Y.; He, P.; Tian, C.; Wang, Y. CgHog1 controls the adaptation to both sorbitol and fludioxonil in Colletotrichum gloeosporioides. Fungal Genet. Biol. B 2020, 135, 103289. [Google Scholar] [CrossRef]
- Tang, H.; Xu, J.; Mingjie, C. Pan1p, End3p, and Sla1p, Three Yeast Proteins Required for Normal Cortical Actin Cytoskeleton Organization, Associate with Each Other and Play Essential Roles in Cell Wall Morphogenesis. Mol. Cell. Biol. 2000, 20, 12–25. [Google Scholar] [CrossRef]
- Li, X.; Gao, C.; Li, L.; Liu, M.; Yin, Z.; Zhang, H.; Zheng, X.; Wang, P.; Zhang, Z. MoEnd3 regulates appressorium formation and virulence through mediating endocytosis in rice blast fungus Magnaporthe oryzae. PLoS Pathog. 2017, 13, e1006449. [Google Scholar] [CrossRef]
- Wessels, J.G.H. Cell Wall Synthesis in Apical Hyphal Growth. Int. Rev. Cytol. 1986, 104, 37–79. [Google Scholar] [CrossRef]
- Chuang, J.S.; Schekman, R.W. Differential trafficking and timed localization of two chitin synthase proteins, Chs2p and Chs3p. J. Cell Biol. 1996, 135, 597–610. [Google Scholar] [CrossRef]
- Wedlich-Söldner, R.; Bölker, M.; Kahmann, R.; Steinberg, G. A putative endosomal t-SNARE links exo- and endocytosis in the phytopathogenic fungus Ustilago maydis. EMBO J. 2000, 19, 1974–1986. [Google Scholar] [CrossRef] [PubMed]
- Perez-Nadales, E.; Di Pietro, A. The transmembrane protein Sho1 cooperates with the mucin Msb2 to regulate invasive growth and plant infection in Fusarium oxysporum. Mol. Plant Pathol. 2015, 16, 593–603. [Google Scholar] [CrossRef]
- Fuchs, B.B.; Mylonakis, E. Our paths might cross: The role of the fungal cell wall integrity pathway in stress response and cross talk with other stress response pathways. Eukaryot. Cell 2009, 8, 1616–1625. [Google Scholar] [CrossRef]
- Levin, D.E. Cell wall integrity signaling in Saccharomyces cerevisiae. Microbiol. Mol. Biol. Rev. 2005, 69, 262–291. [Google Scholar] [CrossRef]
- Zhang, X.; Liu, W.; Li, Y.; Li, G.; Xu, J.R. Expression of HopAI interferes with MAP kinase signalling in Magnaporthe oryzae. Environ. Microbiol. 2017, 19, 4190–4204. [Google Scholar] [CrossRef]
- Xu, J.R.; Staiger, C.J.; Hamer, J.E. Inactivation of the mitogen-activated protein kinase Mps1 from the rice blast fungus prevents penetration of host cells but allows activation of plant defense responses. Proc. Natl. Acad. Sci. USA 1998, 95, 12713–12718. [Google Scholar] [CrossRef] [PubMed]
- Yong, H.Y.; Abu Bakar, F.; Illias, R.; Mahadi, N.M.; Abdul Murad, A.M. Cgl-SLT2 is required for appressorium formation, sporulation and pathogenicity in Colletotrichum gloeosporioide. Braz. J. Microbiol. 2013, 44, 1241–1250. [Google Scholar] [CrossRef] [PubMed]
- Nan, Z.; Zhi-Qiang, L.; Man-Li, W.U.; Xiao-Yu, L.I. Gene cloning and functional analysis of CgSho1 in Colletotrichum gloeosporioides. Acta Phytopathol. Sin. 2017, 47, 40–49. [Google Scholar] [CrossRef]
- Choi, J.; Kim, K.S.; Rho, H.S.; Lee, Y.H. Differential roles of the phospholipase C genes in fungal development and pathogenicity of Magnaporthe oryzae. Fungal Genet. Biol. B 2011, 48, 445–455. [Google Scholar] [CrossRef] [PubMed]
- Jiang, L.; Wang, J.; Asghar, F.; Snyder, N.; Cunningham, K.W. CaGdt1 plays a compensatory role for the calcium pump CaPmr1 in the regulation of calcium signaling and cell wall integrity signaling in Candida albicans. Cell Commun. Signal. 2018, 16, 33. [Google Scholar] [CrossRef]
- Blankenship, J.R.; Wormley, F.L.; Boyce, M.K.; Schell, W.A.; Filler, S.G.; Perfect, J.R.; Heitman, J. Calcineurin is essential for Candida albicans survival in serum and virulence. Eukaryot. Cell 2003, 2, 422–430. [Google Scholar] [CrossRef]
- Chen, Y.-L.; Lehman, V.N.; Lewit, Y.; Averette, A.F.; Heitman, J. Calcineurin governs thermotolerance and virulence of Cryptococcus gattii. G3 (Bethesda) 2013, 3, 527–539. [Google Scholar] [CrossRef] [PubMed]
- Lamoth, F.; Juvvadi, P.R.; Gehrke, C.; Steinbach, W.J. In vitro activity of calcineurin and heat shock protein 90 Inhibitors against Aspergillus fumigatus azole- and echinocandin-resistant strains. Antimicrob. Agents Chemother. 2013, 57, 1035–1039. [Google Scholar] [CrossRef]
- Fudal, I.; Collemare, J.; Böhnert, H.U.; Melayah, D.; Lebrun, M.H. Expression of Magnaporthe grisea avirulence gene ACE1 is connected to the initiation of appressorium-mediated penetration. Eukaryot. Cell 2007, 6, 546–554. [Google Scholar] [CrossRef]
- Pérez-Nadales, E.; Di Pietro, A. The membrane mucin Msb2 regulates invasive growth and plant infection in Fusarium oxysporum. Plant Cell 2011, 23, 1171–1185. [Google Scholar] [CrossRef] [PubMed]
- Zhang, J.; Zhang, Y.; Yang, J.; Kang, L.; Elo, R.A.; Zhou, H.; Zhao, J. The α-1,6-mannosyltransferase VdOCH1 plays a major role in microsclerotium formation and virulence in the soil-borne pathogen Verticillium dahliae. Fungal Biol. 2019, 123, 539–546. [Google Scholar] [CrossRef]
- Tamura, K.; Stecher, G.; Peterson, D.; Filipski, A.; Kumar, S. MEGA6: Molecular Evolutionary Genetics Analysis version 6.0. Mol. Biol. Evol. 2013, 30, 2725–2729. [Google Scholar] [CrossRef]
- Patnaik, S.R.; Raghupathy, R.K.; Zhang, X.; Mansfield, D. The Role of RPGR and Its Interacting Proteins in Ciliopathies. J. Ophthalmol. 2015, 2015, 414781. [Google Scholar] [CrossRef]
- Wilson, R.; Gibson, R.; Quispe, C.; Littlechild, J.; Talbot, N. An NADPH-Dependent Genetic Switch Regulates Plant Infection by the Rice Blast Fungus. Proc. Natl. Acad. Sci. USA 2010, 107, 21902–21907. [Google Scholar] [CrossRef] [PubMed]
- Sweigard, J.; Carroll, A.; Farrall, L.; Valent, B. A series of vectors for fungaltransformation. Fungal Genet. Rep. 1997, 44, 52–53. [Google Scholar] [CrossRef]
- Livak, K.J.; Schmittgen, T.D. Analysis of relative gene expression data using real-time quantitative PCR and the 2(-Delta Delta C(T)) Method. Methods 2001, 25, 402–408. [Google Scholar] [CrossRef] [PubMed]

| Primer Name | Sequence | Use in This Study |
|---|---|---|
| CgEnd3-5Ffor (1F) | AGACTGGCCAAAAGTGTTCG | 5F flanking sequence |
| CgEnd3-5Frev (2R) | CTCCCACAGGAATCTCCGTC | |
| CgEnd3-3Ffor (2F) | TACGCTTCGATACCCTTCGG | 3F flanking sequence |
| CgEnd3-3Frev (3R) | CTTGGAGCGACAAGTTGGGA | |
| External-CgEnd3for (3F) | TTCCTAGCGACCCTGTTGTT | External sequence used for validation of mutant |
| External-CgEnd3rev (4R) | GCCCGGTGAGTAGAATGGTA | |
| Internal-CgEnd3for (4F) | AATAACAACCCCGCCTCTTC | Internal sequence used for validation of mutant |
| Internal-CgEnd3rev (5R) | AGCTGCTTCTTGAGCCTGAC | |
| CgEnd3-Compfor | TCGACTCGACAACATCAAGC | Complementary sequence |
| CgEnd3-Comprev | GCCCGGTGAGTAGAATGGTA | |
| SUR-5′-M13F | CGCCAGGGTTTTCCCAGTCACGACGTCGACGTGCCAACGCCACAG | Sur cassette contains the region of M13F and M13R |
| SUR-3′-M13R | AGCGGATAACAATTTCACACAGGAGTCGACGTGAGAGCATGCAAT | |
| SU-SPLIT | CCAAGCATGTGCAGTGCCTTC | The 2/3rd portion of the Sur cassette |
| UR-SPLIT | GGAGGCCGACGTCATAGGCATC | |
| CgPMC1-f | CATCATGATTGCTGGTCAGG | qRT-PCR of CgPMC1 |
| CgPMC1-r | GACACCGAAAGGAATGGAAA | |
| CgNCS1-f | AGCGACAAGTCAGGAAGCAT | qRT-PCR of CgNCS1 |
| CgNCS1-r | CCTCGACGATCTTGAGCATT | |
| CgCAM1-f | ACAACAACGGCTTCATCTCC | qRT-PCR of CgCAM1 |
| CgCAM1-r | GCGAATCATCTCGTCAACCT | |
| CgCRZ1-f | AGGTCGGATCTGCATCAAAC | qRT-PCR of CgCRZ1 |
| CgCRZ1-r | ATGTACTGGCCGCTGGTATC | |
| CgCAMK1-f | ATGCTGAAGAAGGGTCATGG | qRT-PCR of CgCAMK1 |
| CgCAMK1-r | TGAAATCCTTGGCATCATCA | |
| CgCHS1-f | GGTGGTGGTCTGAAGCGTTA | qRT-PCR of CgCHS1 |
| CgCHS1-r | AGCGCATCTTGTGGAACTCA | |
| CgCHS2-f | GACTACGCCCGCGAATATGA | qRT-PCR of CgCHS2 |
| CgCHS2-r | GTTCGTAGATGCCGGAAGGA | |
| CgCHS3-f | CACCGGCTACAGCGAGTATG | qRT-PCR of CgCHS3 |
| CgCHS3-r | CAAGTTTCCGCGGTACAGGA | |
| CgCHS4-f | CGACAAGGACCATCCGAACT | qRT-PCR of CgCHS4 |
| CgCHS4-r | GCGAGGCATCGGAGTAGTTA | |
| CgCHS5-f | CTCAGGGCGGCATTGATACT | qRT-PCR of CgCHS5 |
| CgCHS5-r | AGTAGAGCGTAGTTGGAGGC | |
| CgCHS6-f | ACCAATCCGGTGCTTATCGG | qRT-PCR of CgCHS6 |
| CgCHS6-r | GGGGTCTCGAAGCCAAGATG | |
| CgCHS7-f | TGGTCAAGGGCCTTCAATGG | qRT-PCR of CgCHS7 |
| CgCHS7-r | ATCACAACCTTTGGTGCGGA | |
| CgDN3-f | CCTACTCGCTGTTCCCTTCA | qRT-PCR of CgDN3 |
| CgDN3-r | CGTGGTCTCCCGGATAGTAG | |
| CgEC6-f | TTGGCAGTATCACCGTGAAG | qRT-PCR of CgEC6 |
| CgEC6-r | TCGATCTCATCCTGGTAGGC | |
| CgFl-f | GCTGTTGAGTCCGGTGGTAT | qRT-PCR of CgFl |
| CgFl-r | GGGTGGTGGTCATAGAGGTG | |
| CgNis1-f | ATCTACGGCATTGCCTTCC | qRT-PCR of CgNis1 |
| CgNis1-r | AGAAGGAGCCGATGACTGTG | |
| Cg18S-f | GTGAGGCCCTCAAAGGTAGTGG | qRT-PCR of Cg18S |
| Cg18S-r | GGATCCCAGTGCGAGACGT |
Publisher’s Note: MDPI stays neutral with regard to jurisdictional claims in published maps and institutional affiliations. |
© 2021 by the authors. Licensee MDPI, Basel, Switzerland. This article is an open access article distributed under the terms and conditions of the Creative Commons Attribution (CC BY) license (https://creativecommons.org/licenses/by/4.0/).
Share and Cite
Wang, X.; Lu, D.; Tian, C. CgEnd3 Regulates Endocytosis, Appressorium Formation, and Virulence in the Poplar Anthracnose Fungus Colletotrichum gloeosporioides. Int. J. Mol. Sci. 2021, 22, 4029. https://doi.org/10.3390/ijms22084029
Wang X, Lu D, Tian C. CgEnd3 Regulates Endocytosis, Appressorium Formation, and Virulence in the Poplar Anthracnose Fungus Colletotrichum gloeosporioides. International Journal of Molecular Sciences. 2021; 22(8):4029. https://doi.org/10.3390/ijms22084029
Chicago/Turabian StyleWang, Xiaolian, Dongxiao Lu, and Chengming Tian. 2021. "CgEnd3 Regulates Endocytosis, Appressorium Formation, and Virulence in the Poplar Anthracnose Fungus Colletotrichum gloeosporioides" International Journal of Molecular Sciences 22, no. 8: 4029. https://doi.org/10.3390/ijms22084029
APA StyleWang, X., Lu, D., & Tian, C. (2021). CgEnd3 Regulates Endocytosis, Appressorium Formation, and Virulence in the Poplar Anthracnose Fungus Colletotrichum gloeosporioides. International Journal of Molecular Sciences, 22(8), 4029. https://doi.org/10.3390/ijms22084029
